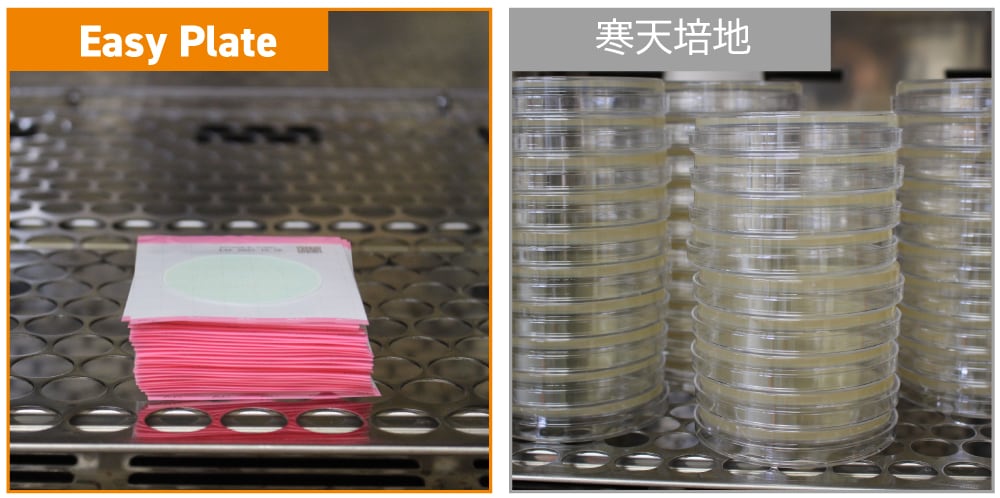

Easy Plateとは
寒天培地による微生物検査で困りごとはありませんか?
食品事業者が微生物検査を行う目的は、微生物汚染のリスクのある食品を製造、加工、販売しないように、製造工程や製造環境のモニタリング、さらに食品中の微生物汚染の有無を確認するためです。
品質管理に関する様々な業務がある中で、効率よく正確に微生物検査を行いたいと感じることはありませんか。ところが、寒天培地による微生物検査には、様々な課題があります。

- 培地調製などの事前準備が大変
- 検査の急な増加で、培地が足りるか心配
- 培養の時間が長く、菌種によって判定までの時間が異なり、報告書作成に手間取る
- 検査技量のばらつきで、測定精度に不安がある
- 微生物検査に関する業務をもっと効率的に行いたい
微生物検査用フィルム培地 Easy Plateは、それらの課題を解決し、食品微生物検査の迅速化、作業者の負担軽減を実現し、食品の安全性向上を可能します!
Easy Plateのおすすめポイント
Easy Plateは、あらかじめ菌の生育に必要な成分を含んだフィルム培地です。そのため、事前準備は不要で、開封後すぐにご使用いただけます。
一般生菌数測定用 Easy Plate ACはバチルス属のコロニーが広がりにくくなっています。また、大腸菌群数測定用 Easy Plate CC、大腸菌・大腸菌群数測定用 Easy Plate EC、黄色ブドウ球菌数測定用 Easy Plate SAは選択性が高いため確認試験の頻度を減らし、検査全体の作業時間を短縮することができます。
それでは、各段階でのフィルム培地と寒天培地での具体的な手順の違いを見てみましょう。
1.準備:培地調製の手間を大幅に削減

- アルミ袋から開封後、すぐに使用できます。
- 大量の実験器具、試薬の秤量、滅菌作業が不要になります。
- 検体数の増減や、急な検査依頼にも柔軟に対応できます。
2.接種:カバーフィルムを開けて、試料液を滴下するだけ

- 10枚まで重ねて、試料液を滴下できます。
- 寒天培地法より早く接種を完了できます。
- どの菌種も同じプロセスで接種するため、効率的に進められます。
3.培養:省スペース
- 25枚まで重ねて省スペースで培養できるので、小型の培養器で大量のサンプルを培養できます。
- 検査スケジュールの調整が容易で、クレーム対応、再検査に迅速に対応できます。
| 製品名・用途 | 培養温度 | 培養時間 |
|---|---|---|
| Easy Plate AC 一般生菌数測定用 | 35±1℃ | 48±2時間 |
| Easy Plate CC 大腸菌群数測定用 | 35±1℃ | 24±1時間 |
| Easy Plate EC 大腸菌・大腸菌群数測定用 | 35±1℃ | 24±1時間 |
| Easy Plate SA 黄色ブドウ球菌数測定用 | 35±1℃ / 37±1℃ | 24±1時間 |
| Easy Plate YM-R 真菌(カビ・酵母)数測定用 | 25±1℃ | 48~72時間 |
| Easy Plate EB 腸内細菌科菌群数測定用 | 35±1℃ / 37±1℃ | 24±1時間 |
| Easy Plate AC-R 一般生菌数測定用 | 35±1℃ | 24±1時間 |
| Easy Plate LS リステリア属菌検査用 | 35±1℃ / 37±1℃ | 24±1時間 |
4.測定:視認性がよく、正確な測定

- 色がついたコロニーのみを計測するため食品残渣と見間違えにくく、コロニーのカウントが容易です。
- 一般生菌数測定用 Easy Plate ACはバチルス属のコロニーが広がりにくくなっています。
5.片付け

- 廃棄量が少なく、滅菌回数を削減できます。
- CO2の削減、廃棄コストの削減に繋がります。
このように、微生物検査用フィルム培地 Easy Plateは、増え続ける品質管理業務の効率化、作業の標準化、省スペース化をサポートします!
微生物検査用フィルム培地 Easy Plate

微生物検査用フィルム培地 Easy Plateは、食品微生物検査の迅速化、作業者の負担軽減を実現し、食品の安全性向上を可能します!
